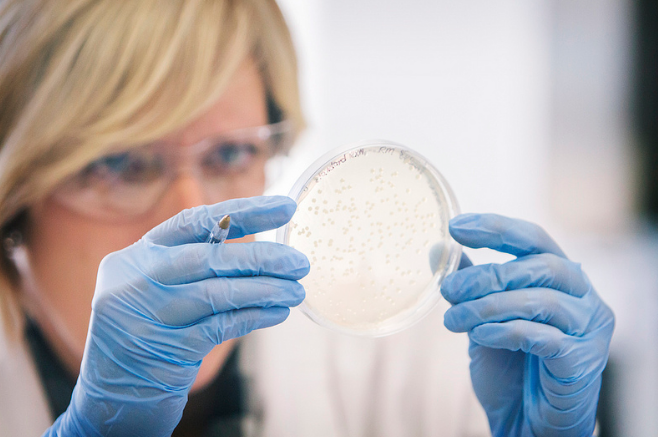

The province of Ontario is partnering with Bioindustrial Innovation Canada, the organisation behind the Bowman Centre biotechnology sector in Sarnia, to support a new biotechnology hub in the area.
The funding will be used to build a Centre of Excellence, which the province said will create 400 jobs.
Ontario will invest $3 million over four years through the Business Growth Initiative, the province’s fund with $400 million dedicated to “creating an innovation-driven economy” and re-examining regulation. The funding will be used to build a Centre of Excellence for the Commercialization of Sustainable Chemistry Innovations at the Western Sarnia-Lambton Research Park, Canada’s largest cleantech incubator.
The Centre will focus on bridging gaps and addressing commercialization challenges faced by companies working in the biotechnology sector; some of these challenges include developing expertise, forging commercial partnerships, and accessing risk capital. The province said that the creation of the Centre will create 400 jobs.
“Ontario’s Business Growth Initiative is supporting highly skilled jobs by promoting an innovation-based economy. This Sarnia-based centre of excellence will provide our province with a powerful new hub to align and advance the commercialization of industrial biotechnologies,” said Reza Moridi, Minister of Research and Innovation. “This strategic investment will help accelerate the great work already taking place at the Western Sarnia-Lambton Research Park and propel Ontario to the forefront of the biotechnology sector, leading to further economic growth and prosperity in the Sarnia-Lambton region.”
Photo courtesy HCC Public Information Office